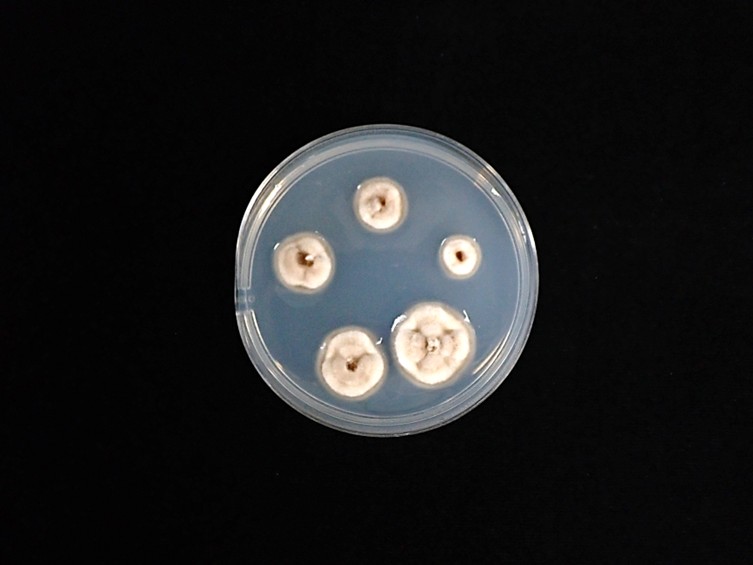

Holotype:
THAILAND, Nakhon Ratchasima Province, Khao Yai National Park, 22 Jul. 2009, K. Tasanathai, S. Mongkolsamrit, P. Srikitikulchai, R. Ridkaew, holotype BBH 30055, ex-type living culture BCC 45127.
Habitat:
Twig of a tree
Host:
On horsefly (Tabanidae, Tabanus sp.).
Description:
 Stromata stipitate, usually two stromata arising from the thorax region of host, beneath the wings, capitate, unbranched. Stipes cylindrical, smooth, tough, brownish-orange, 4–10 mm long, 1.5–2 mm wide. Sexual morph: Fertile head hemispherical to globoid, upper surface slightly convex, moderate orange, located at the terminal part of stipes, 2–3 mm thick, 3–4 mm diam.
Stromata stipitate, usually two stromata arising from the thorax region of host, beneath the wings, capitate, unbranched. Stipes cylindrical, smooth, tough, brownish-orange, 4–10 mm long, 1.5–2 mm wide. Sexual morph: Fertile head hemispherical to globoid, upper surface slightly convex, moderate orange, located at the terminal part of stipes, 2–3 mm thick, 3–4 mm diam.  Perithecia immersed, ovoid to obclavate, 1000–1180 × 320–450 μm.
Perithecia immersed, ovoid to obclavate, 1000–1180 × 320–450 μm.  Asci cylindrical, 550–880 × 4–6 μm with cap 3–6 μm thick. Ascospores filiform, multi-septate, breaking into 64 part-spores, cylindrical to fusoid, 10–14 × 1–2 μm. Asexual morph:
Asci cylindrical, 550–880 × 4–6 μm with cap 3–6 μm thick. Ascospores filiform, multi-septate, breaking into 64 part-spores, cylindrical to fusoid, 10–14 × 1–2 μm. Asexual morph:  Synnemata usually arising from posterior abdomen region of host, solitary, cylindrical, unbranched, uneven and rough when aged, brown to dark brown at the base, moderate orange at the apex, 5–10 × 0.5–2 mm, fertile part located at the terminal ends of the synnemata.
Synnemata usually arising from posterior abdomen region of host, solitary, cylindrical, unbranched, uneven and rough when aged, brown to dark brown at the base, moderate orange at the apex, 5–10 × 0.5–2 mm, fertile part located at the terminal ends of the synnemata.  Conidiogenous cells hymenostilbe-like, phialidic, forming a hymenial layer. Phialides cylindrical with short crowded denticles, 12–20 × 3–4 μm.
Conidiogenous cells hymenostilbe-like, phialidic, forming a hymenial layer. Phialides cylindrical with short crowded denticles, 12–20 × 3–4 μm.  Conidia hyaline smooth-walled, fusoid, 5–10 × 3–4 μm.
Conidia hyaline smooth-walled, fusoid, 5–10 × 3–4 μm.
Culture characteristics:
Colonies on PDA attaining a diam of 10 mm in 30 d, high mycelium density, white, reverse pale yellow. Conidia and reproductive structures not observed.
PDA attaining a diam of 10 mm in 30 d, high mycelium density, white, reverse pale yellow. Conidia and reproductive structures not observed.
Reference:
Mongkolsamrit S, Thanakitpipattana D, Noisripoom W, et al. (2025). Multi-locus molecular phylogenetic analysis reveals four new species and a new record of Ophiocordyceps (Ophiocordycipitaceae, Hypocreales) on dipteran hosts in Thailand. MycoKeys 119: 235–261.
DOI: https://doi.org/10.3897/mycokeys.119.155439Species |
Strain |
Compound |
Pubchem CID |
Biological activity |
Reference |
|---|
|
Strain |
- | PV170901 |
|---|---|---|
| BCC 39918 | - | - |
| BCC 45127 | - | - |